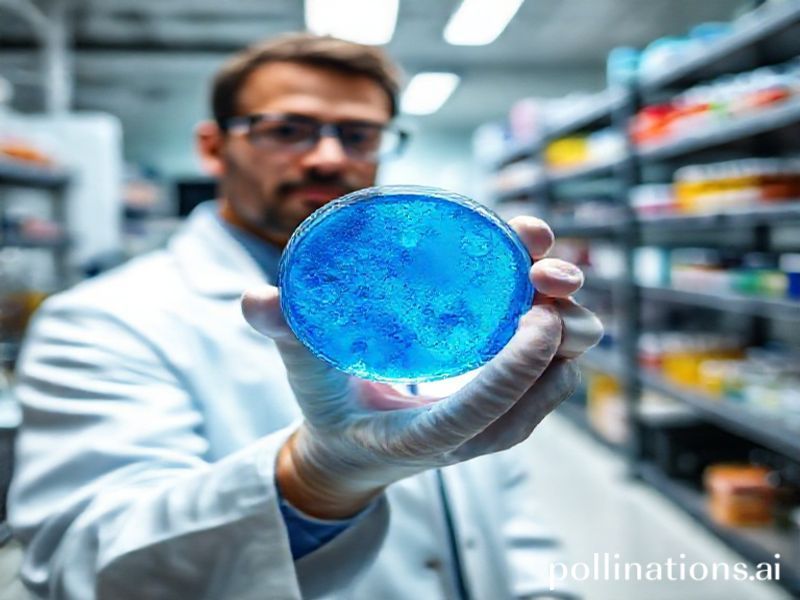
Trending: result

The ‘Result’ Revolution: Why the World is Obsessed with Outcomes
The “Result” Revolution: Why the World is Obsessed with Outcomes
In the vast, chaotic digital landscape, one word has risen to the top of the trending charts like a perfectly timed meme: “result.” But why is everyone talking about it? Is it the latest TikTok dance, a new Netflix series, or perhaps a groundbreaking scientific discovery? Not quite. The “result” trend is more about the collective global obsession with outcomes, achievements, and the sweet, sweet satisfaction of seeing our efforts pay off.
The Cultural Context: From KPIs to KPIs
In a world where we’re constantly bombarded with data, metrics, and key performance indicators (KPIs), it’s no surprise that “result” has become a buzzword. We’re living in an era where everything is quantifiable, from our fitness levels (thanks, Fitbit) to our social media engagement (hello, Instagram Insights). We’re a society that’s obsessed with tracking, measuring, and optimizing every aspect of our lives.
This cultural shift has been fueled by the rise of the gig economy, where freelancers and independent contractors are constantly hustling to prove their worth. In this landscape, “result” isn’t just a word—it’s a currency. It’s the tangible proof of your skills, your dedication, and your ability to deliver.
The Social Impact: The Rise of the “Result” Meme
The “result” trend has also given birth to a new wave of memes and internet culture. From the infamous “Distracted Boyfriend” meme to the “Woman Yelling at a Cat” meme, the internet has always had a knack for turning everyday situations into viral sensations. The “result” meme is no different.
The “result” meme typically features a before-and-after scenario, with the “result” being the satisfying, often hilarious, outcome. For example, a popular “result” meme shows a chaotic, messy situation (like a cluttered room) followed by a perfectly organized space (the “result”). These memes resonate with us because they tap into our collective desire for order, control, and, of course, results.
The Significance: Why “Result” Matters
So, why does the “result” trend matter? For starters, it reflects our society’s growing obsession with productivity, efficiency, and achievement. In a world where we’re constantly being judged on our output, the “result” trend serves as a reminder that our efforts do, in fact, matter.
Moreover, the “result” trend highlights the power of visual storytelling. In an age where attention spans are shrinking and information is abundant, the ability to convey a message quickly and effectively is more important than ever. The “result” meme does just that—it tells a story in a single, easily digestible image.
The Dark Side: The Pressure to Perform
However, the “result” trend also has a darker side. In our quest for outcomes, we often overlook the process—the journey, the struggles, the failures. This can lead to a culture of perfectionism, where anything less than a stellar “result” is seen as a failure.
Furthermore, the “result” trend can perpetuate the idea that our worth is tied to our productivity. In a society that already glorifies hustle culture, the “result” trend can add to the pressure to always be performing, always be achieving, always be delivering.
Conclusion: The “Result” Revolution
In conclusion, the “result” trend is more than just a viral meme—it’s a reflection of our society’s obsession with outcomes, achievements, and the satisfaction of seeing our efforts pay off. It’s a testament to our collective desire for order, control, and productivity. But it’s also a reminder that the journey is just as important as the destination.
So, the next time you see a “result” meme, take a moment to appreciate the process behind it. After all, every great “result” is the product of countless hours of hard work, dedication, and perseverance. And that, my friends, is a trend worth celebrating.